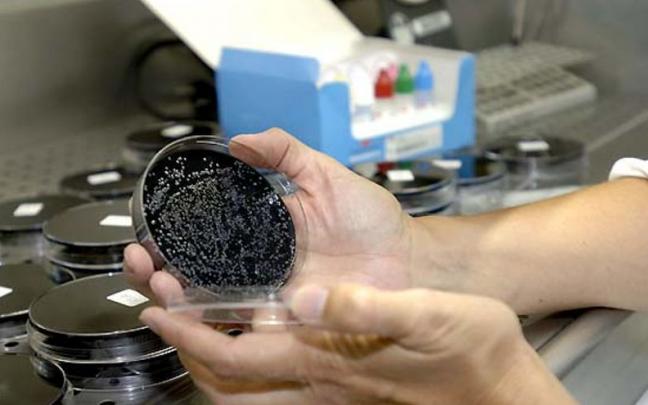
Realización de pruebas para determinar la existencia de Legionella

El 70% de las 1.220 personas diagnosticadas en Navarra con VIH son hombres
El Departamento de Salud del Gobierno de Navarra y las entidades que luchan contra el virus de inmunodeficiencia humana (VIH) en la Comunidad Foral conmemoran mañana, 1 de diciembre, el Día Mundial del…

Uno de cada cuatro navarros reconoce tener un bajo bienestar emocional
Salud Pública pone el foco en las desigualdades como factor de riesgo y realizará un diagnóstico de las zonas de alta vulnerabilidad

La circulación de virus respiratorios descendió la semana pasada en Navarra
Salud Pública detecta una circulación esporádica de la gripe y del coronavirus con intensidad y gravedad en niveles bajos y tendencia estable / Bajan los casos confirmados de covid-19 por cuarta semana consecutiva

Aconsejan la figura de un coordinador cultural para solucionar los conflictos laborales de Tudela Cultura
El ISPLN constata falta de comunicación entre trabajadores y gerencia y aconseja el traslado de un empleado

El poder adquisitivo de los trabajadores navarros, en su peor momento en una década
El encarecimiento de la energía y las materias primas, unido a la inflación disparada, hunde la capacidad de unos salarios que ya estaban mermados desde la crisis de 2012

“Mi nieta y mi mujer me dan esa alegría y esas ganas de seguir; mi principal objetivo es vivir el máximo tiempo posible”
Ángel Álava, tudelano de 62 años y paciente de ELA desde 2018, pide más investigación

Inés Pascal: "Aún hay muchos sitios a los que no puedo entrar y eso que mi discapacidad es obvia"
La atrofia muscular espinal no frena a Inés Pascal. A sus 21 años, ha terminado Periodismo y quiere publicar un libro. "Hay momentos en los que pienso vaya mierda porque dependo de otras personas o porque…

Exigen más recursos para los 2.100 navarros que padecen enfermedades raras
Navarra reconoce hasta 73 enfermedades raras, mientras el Ministerio solo registra 22
Navarra ha detectado 32 casos de legionelosis en lo que va de año
Salud Pública informa que suele haber 35-40 casos al año y que la enfermedad es difícil que se desarrolle en personas sanas

Un vecino de Zizur, afectado por el brote de legionella: "Somos más de 220 familias con la misma caldera"
Vecinos del barrio de Santa Cruz no han podido usar agua caliente en los últimos días

5.500 jóvenes participan en las acampadas y travesías autorizadas en Navarra este verano
El Instituto Navarro de la Juventud ha tramitado los expedientes de 51 acampadas y 74 travesías de junio a septiembre, la mayoría en el valle del Roncal

El Instituto Navarro del Deporte programa 21 cursos gratuitos sobre primeros auxilios
Se desarrollarán durante el segundo semestre del año, de forma online y presencial, y se destinan a personal que ejerce las profesiones del deporte















